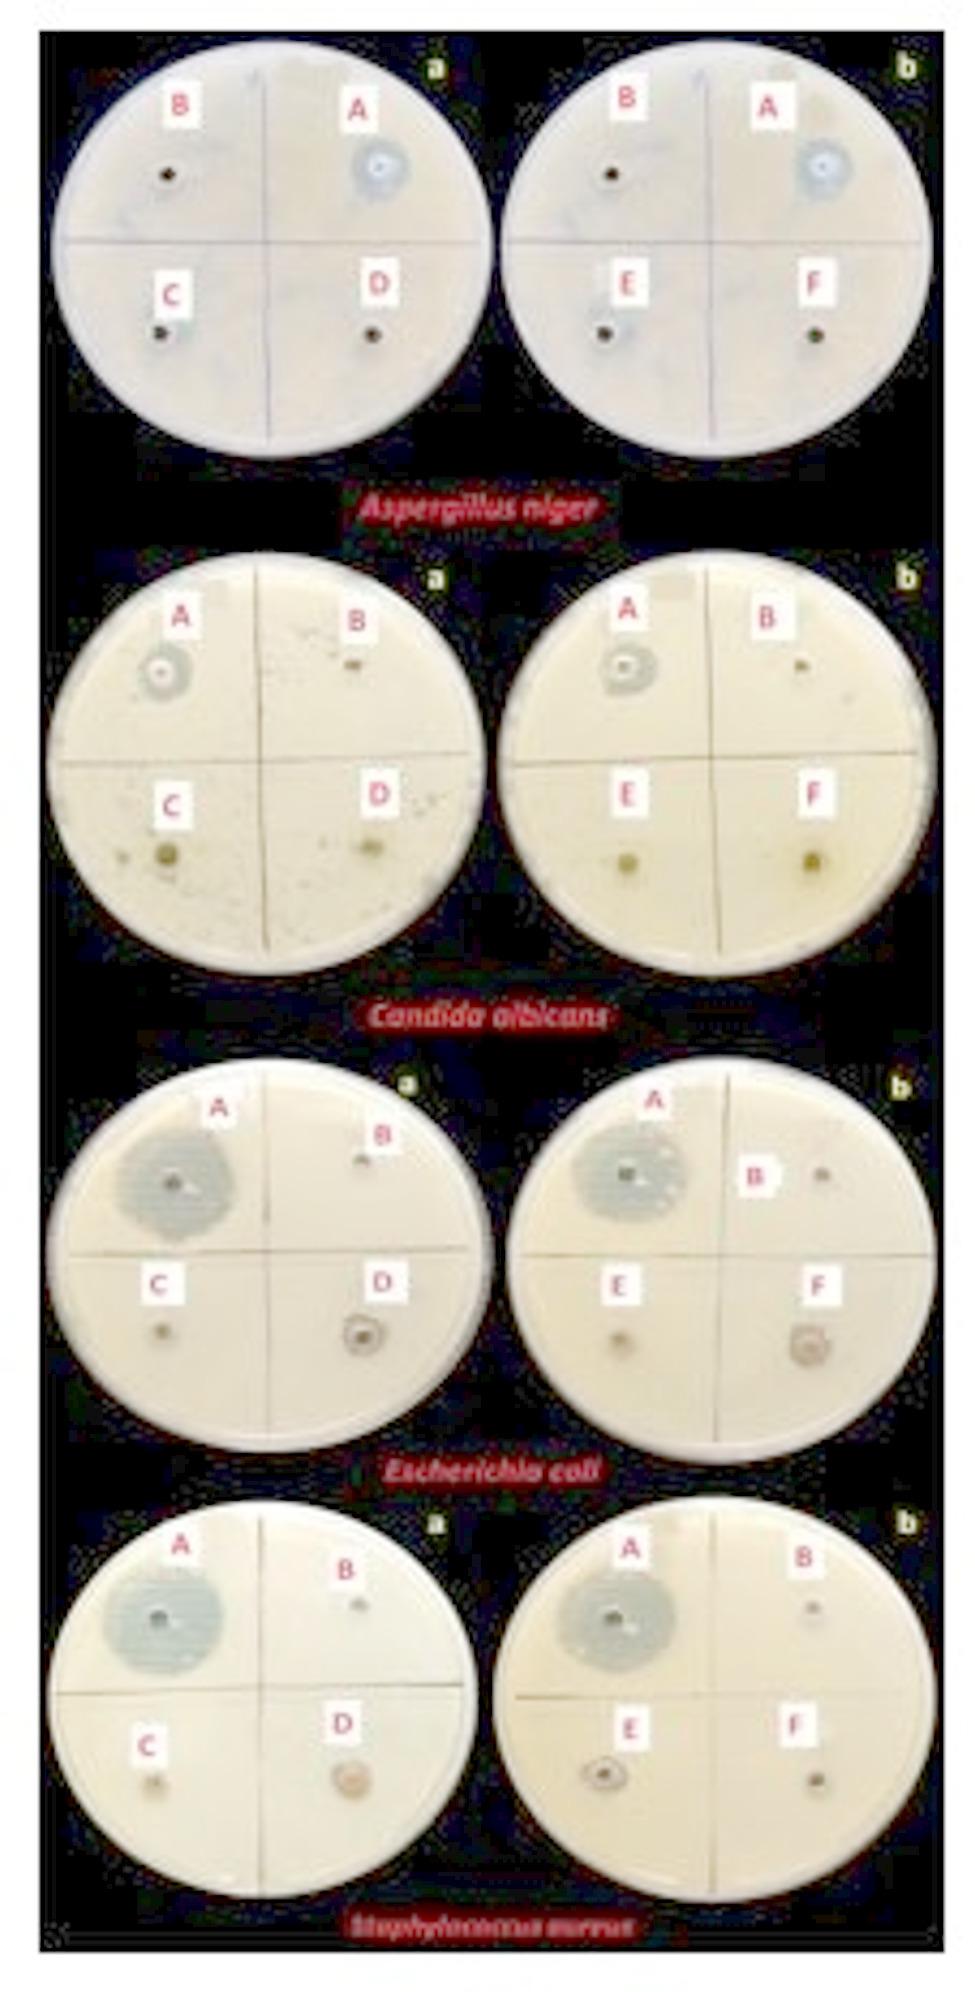

神圣的动物(亚洲象)可以成为药物储存库:使用粪便样本的甲醇提取物治疗结肠癌的新方法及其抗菌,细胞毒性和凋亡作用的评估。
IF 3.4
2区 医学
Q1 INTEGRATIVE & COMPLEMENTARY MEDICINE
引用次数: 0
摘要
本文章由计算机程序翻译,如有差异,请以英文原文为准。

Is sacred animal (Asian Elephant) can be a medicinal repository: a new approach for colon cancer treatment using the methanolic extracts of the dung samples and their valuation for antimicrobial, cytotoxic, and apoptotic actions.
求助全文
通过发布文献求助,成功后即可免费获取论文全文。
去求助
来源期刊

BMC Complementary Medicine and Therapies
INTEGRATIVE & COMPLEMENTARY MEDICINE-
CiteScore
6.10
自引率
2.60%
发文量
300
审稿时长
19 weeks
期刊介绍:
 求助内容:
求助内容: 应助结果提醒方式:
应助结果提醒方式:


